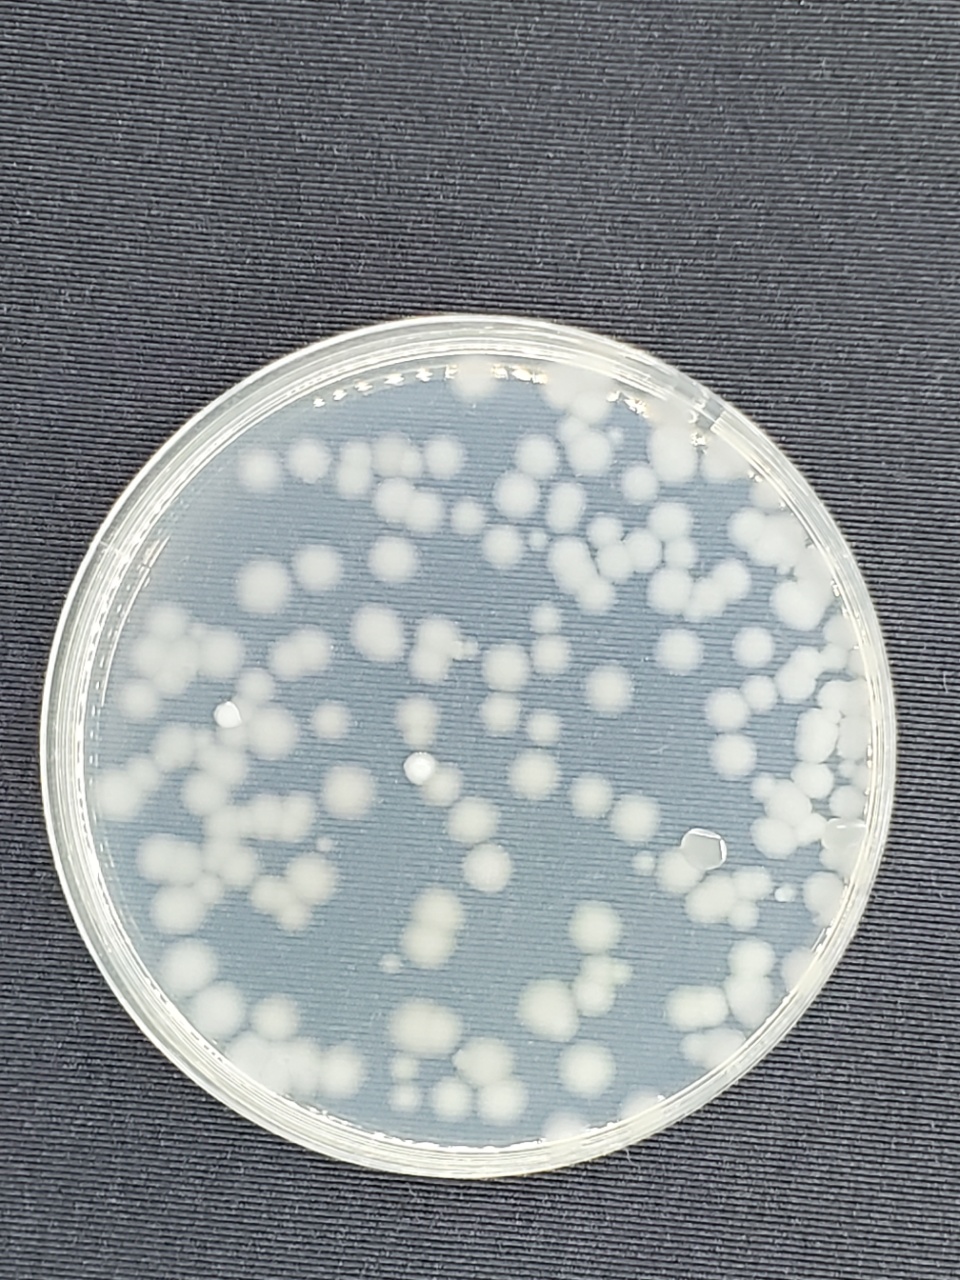

商品详情
喀斯特有机沃柑
产地:广西桂林
规格:5斤/件(纸箱包装)
标准:有机认证

沃柑内含有丰富的次生代谢物质,呈现出层次感醇厚的香甜味道,食用后唇齿留香,喉韵清爽!
一、生草栽培,人工除草。
效仿野生的生态环境,在不同季节让果树处于不同的胁迫状态,合成多种次生代谢产物,形成药食同源的有益物质,使果子具有多层次的芳香口感!


二、与虫共生。
昆虫适当危害能让果树进入次生代谢过程,形成另外的更丰富的次生代谢产物,让果子的风味物质更丰富,果香更浓郁!




三、自制有机肥。
提供并激活多种矿物质,让果树进入次生代谢过程后,有充足的微量元素去完成代谢过程,产生种类繁多的芳香物质,让果子更香更甜,还保有一定的果酸,让果糖在人体内能够运化成为能量。




四、微生物防控黄龙病。
赋予果树第二基因,让果子带着益生菌和益生元,呵护我们的健康!

五、桂林的好山好水自然生长。
在清洁干净的环境中生长,能够让果子带着天然的芳华!





六、持续多年好评。
多年来的优秀品质,逐渐积累品牌价值,给您带来味蕾享受的同时,获得友善的心灵寄托!





- 全食健康生活
- 全食健康生活是健康生活服务平台,提供天然健康产品,平台涉及12大品类,1000多种健康产品,从田园到餐桌全程严格把控,守护你我的健康生活! 好食材,好健康,好生活,好环境!
- 扫描二维码,访问我们的微信店铺